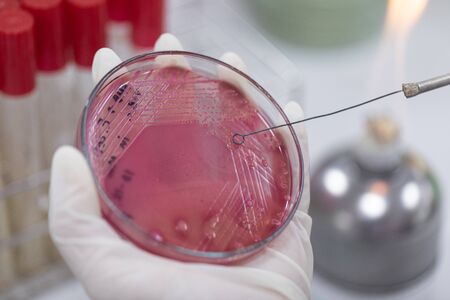
Streak plate for Bacteria culture or identify Bacteria research in labmicrology.の写真素材

写真素材 - Streak plate for Bacteria culture or identify Bacteria research in labmicrology.
作品情報
Streak plate for Bacteria culture or identify Bacteria research in labmicrology.
- ID:136988160
- 作品種別:写真
- 作者名:sinhyu
キーワード
- agar
- analysis
- aseptic
- background
- bacteria
- bacterium
- biochemistry
- biology
- biotechnology
- cell
- cells
- chemistry
- colony
- culture
- development
- disease
- dish
- doctor
- drug
- equipment
- experiment
- health care
- hygiene
- infectious
- isolated
- lab
- laboratory
- medical
- medicine
- micro
- microbiology
- organism
- pathogen
- petri
- petri dish
- pharmaceutical
- plate
- research
- researcher
- resistance
- sample
- science
- scientific
- scientist
- sepsis
- spread plate
- streak
- technique
- technology
- test
類似作品
Close up view r...
bacteria colony...
Close-up of a s...
bacteria colony...
colony of becte...
Macro close up ...
Cells that caus...
Bacteria on a w...
Dynamic motion ...
Close-up of bac...
Close-up of pet...
Ascariasis is a...
Backgrounds of ...
Microscopic bac...
Pills encircle ...
Visualization o...
Examining bacte...
Bacteria on a s...
An overhead, to...
microbial cultu...
Petri dish with...
Close-up of ger...
A detailed obse...
High-res image ...
Helicobacter py...
detail of bacte...
A close-up of b...
Colorful bacter...
microbial cultu...
macro of bacter...
Surface contami...
Close up of bac...
Enterobacterias...
Backgrounds of ...
Microscopic Vie...
Vibrant 3D rend...
bacteria colony...
Conceptual imag...
Diverse colorfu...
Colonies of dif...
Bacteria of dif...
microbial cultu...
Surface with ba...
Blue bacteria w...
Bacteria. Bacte...
close-up of col...
Backgrounds of ...
Abstract wooden...